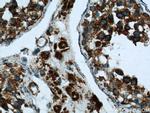
ATP5O Antibody in Immunohistochemistry (Paraffin) (IHC (P))

Search
Proteintech
ATP5O Polyclonal Antibody
{{$productOrderCtrl.translations['antibody.pdp.commerceCard.promotion.promotions']}}
{{$productOrderCtrl.translations['antibody.pdp.commerceCard.promotion.viewpromo']}}
{{$productOrderCtrl.translations['antibody.pdp.commerceCard.promotion.promocode']}}: {{promo.promoCode}} {{promo.promoTitle}} {{promo.promoDescription}}. {{$productOrderCtrl.translations['antibody.pdp.commerceCard.promotion.learnmore']}}
产品信息
10994-1-AP
种属反应
已发表种属
宿主/亚型
分类
类型
抗原
偶联物
形式
浓度
规格
纯化类型
保存液
内含物
保存条件
运输条件
产品详细信息
Immunogen sequence: MAAPAVSGL SRQVRCFSTS VVRPFAKLVR PPVQVYGIEG RYATALYSAA SKQNKLEQVE KELLRVAQIL KEPKVAASVL NPYVKRSIKV KSLNDITAKE RFSPLTTNLI NLLAENGRLS NTQGVVSAFS TMMSVHRGEV PCTVTSASPL EEATLSELKT VLKSFLSQGQ VLKLEAKTDP SILGGMIVRI GEKYVDMSVK TKIQKLGRAM REIV (1-213 aa encoded by BC021233)
靶标信息
The protein encoded by this gene is a component of the F-type ATPase found in the mitochondrial matrix. F-type ATPases are composed of a catalytic core and a membrane proton channel. The encoded protein appears to be part of the connector linking these two components and may be involved in transmission of conformational changes or proton conductance.
仅用于科研。不用于诊断过程。未经明确授权不得转售。
生物信息学
蛋白别名: ATP synthase peripheral stalk subunit OSCP, mitochondrial; ATP synthase subunit O; ATP synthase subunit O, mitochondrial; ATP synthase, H+ transporting, mitochondrial F1 complex, O subunit; ATP synthase, H+ transporting, mitochondrial F1 complex, O subunit (oligomycin sensitivity conferring protein); ATP synthase, H+ transporting, mitochondrial F1 complex, O subunit; DNA segment, Chr 12, Wayne State University 28, expressed; ATP5O; human ATP synthase OSCP subunit; Oligomycin sensitivity conferral protein; oligomycin sensitivity conferral protein oscp-like protein; oligomycin sensitivity conferring protein; OSCP; Sperm flagella protein 4; unnamed protein product
基因别名: ATP5O; ATP5PO; ATPO; D12Wsu28e; HMC08D05; MC5DN7; OSCP
UniProt ID: (Human) P48047, (Mouse) Q9DB20, (Rat) Q06647
Entrez Gene ID: (Human) 539, (Mouse) 28080, (Rat) 192241